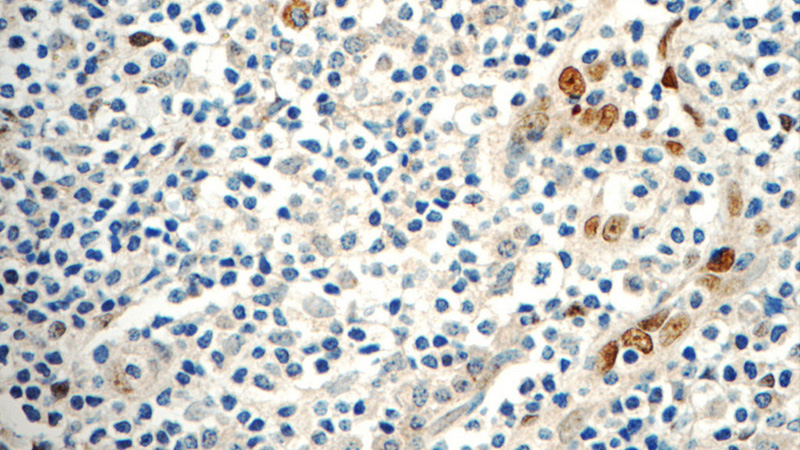
Immunohistochemistry of paraffin-embedded human tonsillitis tissue slide using Catalog No:111738(IL33 Antibody) at dilution of 1:50 (under 40x lens)

-
Product Name
IL33 antibody
- Documents
-
Description
IL33 Rabbit Polyclonal antibody. Positive IHC detected in human tonsillitis tissue. Positive WB detected in Transfected HEK-293 cells, HeLa cells, Recombinant protein.
-
Tested applications
ELISA, IHC, WB
-
Species reactivity
Human; other species not tested.
-
Alternative names
C9orf26 antibody; DKFZp586H0523 antibody; DVS27 antibody; IL 1F11 antibody; IL 33 antibody; IL1F11 antibody; IL33 antibody; Interleukin 1 family member 11 antibody; interleukin 33 antibody; NF HEV antibody; NFEHEV antibody; NFHEV antibody; RP11 575C20.2 antibody
-
Isotype
Rabbit IgG
-
Preparation
This antibody was obtained by immunization of IL33 recombinant protein (Accession Number: NM_001314045). Purification method: Antigen affinity purified.
-
Clonality
Polyclonal
-
Formulation
PBS with 0.1% sodium azide and 50% glycerol pH 7.3.
-
Storage instructions
Store at -20℃. DO NOT ALIQUOT
-
Applications
Recommended Dilution:
WB: 1:200-1:2000
IHC: 1:20-1:200
-
Validations

Transfected HEK-293 cells were subjected to SDS PAGE followed by western blot with Catalog No:111738(IL33 Antibody) at dilution of 1:700

Immunohistochemistry of paraffin-embedded human tonsillitis tissue slide using Catalog No:111738(IL33 Antibody) at dilution of 1:50 (under 10x lens)
Immunohistochemistry of paraffin-embedded human tonsillitis tissue slide using Catalog No:111738(IL33 Antibody) at dilution of 1:50 (under 40x lens)
-
Background
IL-33 is an IL-1 family cytokine and nuclear alarmin, is constitutively expressed in epithelial barrier tissues and human blood vessels. IL-33 is involved in the maturation of Th2 cells and the activation of mast cells, basophils, eosinophils and natural killer cells. It also acts as a chemoattractant for Th2 cells, and may function as an "alarmin", that amplifies immune responses during tissue injury.
-
References
- Li S, Li X, Wang Y, Yang J, Chen Z, Shan S. Global secretome characterization of A549 human alveolar epithelial carcinoma cells during Mycoplasma pneumoniae infection. BMC microbiology. 14:27. 2014.
- Li P, Ma H, Han D, Mou K. Interleukin-33 affects cytokine production by keratinocytes in vitiligo. Clinical and experimental dermatology. 40(2):163-70. 2015.
Related Products / Services
Please note: All products are "FOR RESEARCH USE ONLY AND ARE NOT INTENDED FOR DIAGNOSTIC OR THERAPEUTIC USE"
